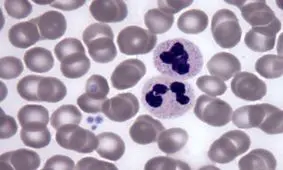
پروتئینی که جلوی پیر شدن را می‌گیرد

جوان ماندن
-

روشهایی برای اینکه در میانسالی جوان تر به نظر برسیم
اگر می خواهید در میانسالی هنوز از جوان برسید باید مراقبت های پوستی و تغذیه سالم و ورزش را از جوانی آغاز کنید.
-

کارهایی که شما را ۲۰ سال جوان تر می کند!
با گذشت زمان و دغدغه های پوچی که برای خودمان ایجاد می کنیم، باعث آسیب به جوانی و سلامت خود می شویم که با رعایت برخی…
-

میوه های نارنجی را بخورید و جوان بمانید
اگر به دنبال کاهش خطوط و چین و چروکهای ظریف چهره خود و جوانتر شدن هستید، روشهایی سادهتر از بوتاکس مثل پیروی از…
-
پروتئینی که جلوی پیر شدن را میگیرد
پژوهشگران اسکاتلندی و انگلیسی در بررسی جدیدی دریافتند که شاید نوعی پروتئین بتواند به حفظ سلامت و جوانی خون کمک کند و…
-

مصرف این خوراکیها برای جوان ماندن پوست معجزه میکند
متخصصان تغذیه معتقد اند که مصرف منظم برخی خوراکیها در یک رژیم غذایی متعادل باعث تقویت پوست و کمک به عملکرد سیستم…
-

این خوراکیها را بخورید تا جوان بمانید
مهم نیست که چقدر مرطوب کنندههای لوکس و سرمهای ضد پیری استفاده میکنید، به هر حال از یک مرحله سنی به بعد، روند پیر…
-

۵ راز مهم برای جوان ماندن
ممکن است نتوانید زمان را به عقب برگردانید، اما میتوانید تأثیر زمان را روی بدن خود تغییر دهید. شاید جالب باشد بدانید…
-

آینده تکنولوژی در درمان پیر شدن انسان
غیر قابل کنترل بودن زمان همیشه باعث افسردگی همه و مخصوصاً دانشمندان است، اما تحقیقات اخیر نشان میدهد که در آیندهای…
-

ارتباط خواب مناسب با جوان ماندن چیست؟
دانشمندان به طور فزایندهای معتقدند که خواب بر عملکرد مغز در طول زمان تأثیر میگذارد و با خطر ابتلا به بیماریهای مغز…
-

5 نکته برای جوان نشان دادن
از رژ لب های سیاه و بنفش و نارنجی پررنگ استفاده نکنید چون چهره شما پیرتر به نظر میرسد
